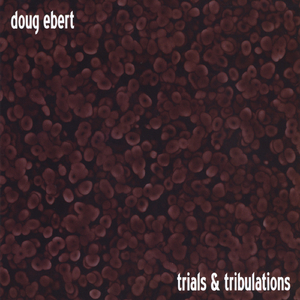
280

280
Simmba

280
Hassan Twil

度母赞 二十一倍的温暖
索达吉堪布

载我回家
张悬

떨어진다 눈물이
Wax

八吉祥颂
索达吉堪布

赶路的少年 (Live)
白小白, 鹭卓, 何浩楠, 王一珩OneSD

280
Dinero

280 (Live)
Saddiq Tazi

280
Jebbah Bentayeb

280 (Live)
Hafid Nadori

280
MW

280 (Live)
Tarik Tito

280 (Live)
Amazrine

280
Tattatore

280
Hullabaloo

280 (Live)
Hullabaloo

280
Disaster Prophet

280
Ser Humano

280
民间音乐世家, 静然寂, 网易云音乐人、作词、作曲、编曲、, n95, 佛儸倫萨的月

280
WELCOME脳

280
Sitek, Voskovy

280
Satia

280
Sterling

cx330Ru
280
280
Doug Ebert

280
297

280
Hype Right

280
DJ零柒Remix

280
Hogan